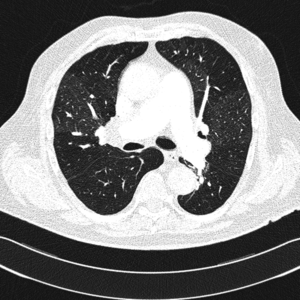
Small 1

150 zł TANIEJ tylko do 23:59 | Weź udział w kongresie online Akademia po Dyplomie PSYCHIATRIA 2026 już 6-7 marca. Kup bilet >
Choroby naczyń
dr hab. n. med. Tomasz Urbanek, Katedra i Klinika Chirurgii Ogólnej i Naczyń SUM, Katowice
Przewlekłe zakrzepowo-zatorowe nadciśnienie płucne
Anna Fijałkowska,1 Andrzej Biederman2
Wprowadzenie
Różnicę między ostrą a przewlekłą zakrzepowo-zatorową chorobą płuc ustalono w latach 50. XX w. Opublikowano wtedy pierwsze dane na temat zespołu przewlekłego zamknięcia dużych tętnic płucnych przez zorganizowane skrzepliny i prób ich operacyjnego usunięcia [1]. Następnie w 1963 r. opisano skuteczny zabieg obustronnej trombendarterektomii płucnej (pulmonary endarterectomy, PEA) [2]. Obecnie wiadomo, że zakrzepowo-zatorowe nadciśnienie płucne (chronic thromboembolic pulmonary hypertension, CTEPH) to potencjalnie wyleczalna operacyjnie forma nadciśnienia płucnego. Postęp, szczególnie w ostatnich 20 latach, w diagnostyce przewlekłego zakrzepowo-zatorowego nadciśnienia płucnego, technikach kardiochirurgicznych i postępowaniu pooperacyjnym pozwala na stałą redukcję ryzyka chirurgicznej trombendarterektomii płucnej. Co równie ważne, dane z ośrodków na całym świecie wykazują, że u prawidłowo kwalifikowanych pacjentów taka forma leczenia operacyjnego przynosi poprawę hemodynamiki krążenia płucnego, wydolności fizycznej pacjentów, a także istotnie wydłuża przeżycie.
Zakrzepowo-zatorowe nadciśnienie płucne: epidemiologia i czynniki ryzyka
Zakrzepowo-zatorowe nadciśnienie płucne to nadciśnienie płucne spowodowane mechanicznym zamknięciem łożyska płucnego przez zorganizowane skrzepliny. Najczęściej jest to niekorzystne zejście epizodu ostrej zatorowości płucnej nazywane przewlekłą zatorowością płucną, a nie pierwotna in situ zakrzepica naczyń płucnych, chociaż w CTEPH klasyczne czynniki ryzyka żylnej choroby zakrzepowo-zatorowej występują rzadko [3]. Według definicji z aktualnych wytycznych Europejskiego Towarzystwa Kardiologicznego z 2009 r. CTEPH należy rozpoznawać przy współistnieniu przedwłośniczkowego nadciśnienia płucnego (średnie ciśnienie w tętnicy płucnej ≥25 mm Hg, ciśnienie zaklinowania w tętnicy płucnej ≤15 mm Hg, naczyniowy opór płucny >2 j. Wooda) i stwierdzeniu w badaniach obrazowych przewlekłych/zorganizowanych zawężających skrzeplin w sprężystych tętnicach płucnych [4]. Zwykle uważa się, że warunkiem rozpoznania CTEPH jest wykrycie przynajmniej jednego segmentalnego defektu perfuzji płucnej w scyntygrafii perfuzyjnej, tomografii komputerowej lub arteriografii tętnicy płucnej.
Dane uzyskane z kilku rejestrów różnią się między sobą i wykazują, że CTEPH występuje w populacji ogólnej w 3-30 przypadkach na milion [3]. Można wnioskować, że w Polsce należy oczekiwać nawet do 1000 chorych z CTEPH. W obserwacjach pacjentów po przebytej ostrej objawowej zatorowości płucnej wykazano, że to odległe powikłanie dotyczy 0,1-9,1% chorych po dwóch latach od ostrego epizodu [5-10]. W ostatnio opublikowanym Europejskim Rejestrze CTEPH wywiad przebytej zatorowości płucnej stwierdzano u 74,8% wszystkich pacjentów z CTEPH, a przebytej zakrzepicy żył głębokich u 56,1% [11]. Brak informacji o ostrym epizodzie nie wyklucza jednak rozpoznania CTEPH.
Tylko kilka czynników specyficznych dla trombofilii jest istotnie statystycznie związanych z CTEPH: obecność przeciwciał antykardiolipinowych, antykoagulantu tocznia i zwiększone stężenie czynnika VIII. Inne znane obecnie kliniczne czynniki ryzyka rozwoju CTEPH to przede wszystkim przebyta lub nawracająca żylna choroba zakrzepowo-zatorowa, przebyte usunięcie śledziony, obecność zastawki komorowo-otrzewnowej w leczeniu wodogłowia, zakażony stymulator serca, nowotwór złośliwy w wywiadzie, a także leczenie substytucyjne tyroksyną. Prawdopodobnie grupa krwi inna niż 0 również predysponuje do rozwoju CTEPH. Sprzyjają mu także przewlekłe stany zapalne: zapalenie kości i szpiku i nieswoiste zapalenie jelit [3,11].
Przebieg naturalny CTEPH
W świetle dostępnych informacji postrzeganie CTEPH tylko jako mechanicznego efektu obliteracji dużych tętnic płucnych przez skrzepliny jest zbyt proste. Niewątpliwie u znacznej części chorych za wzrost naczyniowego oporu płucnego, poza mechaniczną przeszkodą, odpowiadają zmiany patofizjologiczne w naczyniach dystalnych również w częściach płuc nieobjętych procesem zakrzepowo-zatorowym. Zmiany te są wywoływane przez uszkodzenie ściany naczyniowej zwiększoną objętością krwi przepływającej pod wyższym ciśnieniem niż fizjologicznie. Prowadzi to do postępującego uszkodzenia coraz mniejszego kalibru naczyń. W obrazie histopatologicznym materiału z biopsji płuc pacjentów z CTEPH w mikronaczyniach stwierdzano obraz podobny do tętniczego nadciśnienia płucnego.
Rozwój CTEPH to najprawdopodobniej postępujący proces przebudowy łożyska płucnego modyfikowany przez infekcje, zjawiska immunologiczne, stan zapalny, krążące i zlokalizowane w tętnicach płucnych komórki macierzyste, leczenie substytucyjne tyroksyną lub nowotwór złośliwy [3]. Swój udział mogą mieć również wykryte u niektórych pacjentów stany nadkrzepliwości, „lepkie” erytrocyty, zwiększona liczba płytek krwi czy występujący u części chorych wariant fibrynogenu oporny na lizę [12]. Najpewniej istotną rolę pełni także nieprawidłowa funkcja śródbłonka, ale ten mechanizm nie jest dokładnie wyjaśniony i wymaga dalszych badań. Spekuluje się, że krążące substancje wazokonstrykcyjne, miejscowe zaburzenia regulacji naczyniowych czynników wzrostu lub predyspozycje genetyczne mogą też uczestniczyć w rozwoju tej nadciśnieniowej arteriopatii płucnej. Trudność w dokładnym rozumieniu patomechanizmu rozwoju CTEPH jest powodowana m.in. brakiem adekwatnego modelu zwierzęcego.
Wzrost naczyniowego oporu płucnego spowodowanego postępującym uszkodzeniem naczyń płucnych prowadzi do przeciążenia prawej komory serca, jej niewydolności i w konsekwencji do zgonu. Przeżycie pacjentów bez odpowiedniego leczenia operacyjnego jest bardzo złe. W jednym z doniesień 5 lat przeżywało 30% pacjentów, jeśli średnie ciśnienie w tętnicy płucnej wynosiło >40 mm Hg, ale tylko 10%, gdy było wyższe niż 50 mm Hg [13]. W obserwacji ośrodka wrocławskiego już średnie ciśnienie w tętnicy płucnej >30 mm Hg oznaczało bardzo złe rokowanie w 3-letniej obserwacji [14].
Objawy kliniczne i diagnostyka pacjenta z podejrzeniem CTEPH
Badania przesiewowe osób po ostrej zatorowości płucnej nie zwiększają liczby rozpoznań CTEPH, ważniejsza zatem wydaje się edukacja pacjentów dotycząca objawów nadciśnienia płucnego (pulmonary hypertension, PH) [10]. Rozpoznawana w okresie hospitalizacji dysfunkcja prawej komory lub cechy PH, zgodnie z zaleceniami ESC, wymagają natomiast wykonania kontrolnego badania echokardiograficznego po 3-6 miesiącach leczenia przeciwzakrzepowego [4]. Zalecenia ESC dotyczące postępowania w CTEPH zamieszczono w tabeli.
Nie istnieją charakterystyczne objawy CTEPH. U każdej osoby z niewyjaśnioną przyczyną duszności wysiłkowej należy podejrzewać nadciśnienie płucne, a każdego chorego z PH powinno diagnozować się pod kątem CTEPH. Wystąpienie objawów przedmiotowych prawokomorowej niewydolności serca sugeruje znamienne zaawansowanie choroby.
Zwykle pierwsze podejrzenie PH stawia się na podstawie wyniku badania echokardiograficznego, gdy szacowana wysokość skurczowego ciśnienia w tętnicy płucnej (systolic pulmonary artery pressure, SPAP) na podstawie pomiaru maksymalnej prędkości fali niedomykalności trójdzielnej przekracza 50 mm Hg. Wykrycie innych cech PH, jak powiększenie prawej komory, objawy jej przeciążenia z zaburzeniem geometrii ruchu przegrody międzykomorowej czy nieprawidłowy charakter spektrum doplerowskiego wyrzutu do tętnicy płucnej, skłania do rozważenia rozpoznania PH już przy wartościach SPAP >36 mm Hg [4]. Przy podejrzeniu PH niezbędna jest pełna diagnostyka, w tym echokardiografia przezprzełykowa i badanie z kontrastem w celu poszukiwania ewentualnego przecieku wewnątrzsercowego.
Diagnostyka różnicowa przyczyn PH wykrytego w badaniu echokardiograficznym zawsze powinna uwzględniać CTEPH, nawet jeśli w badaniach czynnościowych układu oddechowego stwierdza się nieprawidłowości. Dotyczy to zaburzeń o typie restrykcyjnym u chorych ze zmianami śródmiąższowymi spowodowanymi przebytymi zawałami płuca i obniżenia pojemności dyfuzyjnej dla tlenku węgla (diffusing capacity for carbon monoxide, DLCO), stwierdzanego u części pacjentów. Znaczna redukcja DLCO powinna nasuwać podejrzenie znacznego uszkodzenia dystalnych odcinków naczyń płucnych [15]. Chorzy z CTEPH mają zwykle prawidłowy poziom utlenowania krwi tętniczej (PaO2) w spoczynku. Przy wysiłku często obserwuje się jednak desaturację wynikającą z nasilonych zaburzeń stosunku wentylacji do perfuzji płuc.
Rutynowe badanie pacjentów z podejrzeniem PH obejmuje najważniejsze elementy określające stopień zaawansowania choroby i uszkodzenia prawej komory, które są najważniejszymi czynnikami prognostycznymi. W ocenie klinicznej określa się klasę czynnościową wg NYHA/WHO i dystans pokonywany w teście 6-minutowego marszu (6MWT). Wykonuje się też oznaczenia stężeń peptydu natriuretycznego typu B (BNP lub NT-proBNP) oraz troponiny sercowej jako biochemicznych markerów przeciążenia i uszkodzenia mięśnia prawej komory.
Klasyczne badanie radiologiczne klatki piersiowej nie rozstrzyga o rozpoznaniu, szczególnie we wczesnym okresie choroby. Wraz z postępem PH poszerza się jednak pień i główne gałęzie tętnic płucnych, a także obserwuje się cechy powiększenia prawej komory serca. Obecność obszarów beznaczyniowych w porównaniu z resztą pól płucnych może budzić podejrzenie CTEPH jako przyczyny PH.